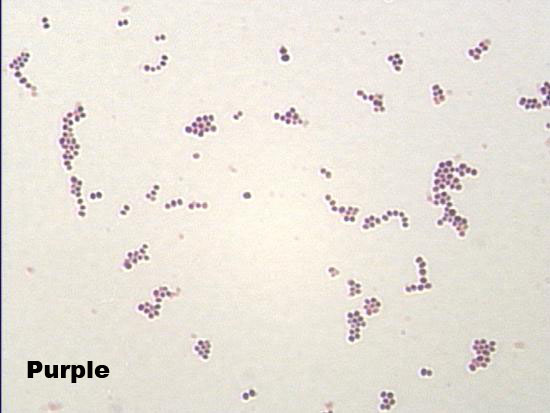

![]()
Created by
Paul A. Gulig, Ph.D.
Department of Molecular Genetics and Microbiology
with assistance from
David Brumbaugh
Here is a micrograph of the results of the Gram stain viewed at 1000X (oil immersion). Without oil immersion to limit light diffraction, you cannot tell much about the morphology or even color of the bacterial cells.
What does this Gram stain show?
What does this Gram stain show?
A. Gram-negative rods.
B. Gram-positive cocci in clumps.
C. Gram-positive cocci in pairs.
D. Gram-positive cocci in chains.
What test do you do next?
A. Coagulase test.
B. Bacitracin (A disk) test
C. Catalase test.
D. Phadebact rapid strep test